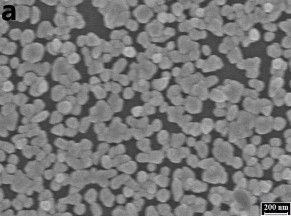
Hình 3 3 Ảnh SEM của AuNP trên bề mặt điện cực GCE với thời gian với thời 2

Hình 3. 2. Ảnh SEM của AuNP trên bề mặt điện cực GCE với thời gian tạo vàng khác nhau: 50 giây (a), 300 giây (b), 600 giây (c)
Như vậy, để thu được lớp vàng có cấu trúc dạng hạt với kích thước hạt nano đồng đều thì thời gian điện phân 600 giây kết tủa vàng lên bề mặt GCE được lựa chọn cho các nghiên cứu tiếp theo.
٭ Ảnh hưởng của khuấy dung dịch đến hình thái bề mặt AuNP

Hình 3. 3. Ảnh SEM của AuNP trên bề mặt điện cực GCE với thời gian với thời gian 600 giây trong điều kiện không khuấy (a) và có khuấy ở tốc độ 60 vòng/phút (b).
Trong quá trình điện phân kết tủa vàng lên bề mặt GCE, ảnh hưởng của khuấy dung dịch điện ly đến việc tạo AuNP lên bề mặt GCE cũng đã được nghiên cứu. Tiến hành khảo sát hình thái của vàng nano khi điện phân không khuấy và có khuấy tại tốc độ khuấy 60 vòng/phút [164]. Kết quả thu được trên hình 3.3 cho thấy ở điều kiện không khuấy, các hạt vàng sắp xếp không đều và trên bề mặt GCE có những vùng không có sự hình thành các tinh thể vàng, xuất hiện vùng các hạt vàng chồng lấn, đan xen nhau tạo nên những hạt vàng kích thước lớn và không còn ở kích thước nanomet. Ngược lại, khi có sự khuấy trộn kích thước các hạt vàng đồng đều ở kích thước
nanomet, số lượng các hạt vàng tăng và che phủ gần kín bề mặt GCE. Hiện tượng này là do khi có sự khuấy trộn, số lượng mầm tinh thể trên bề mặt điện cực tăng, do vậy làm tăng số lượng hạt vàng được tạo thành. Mặt khác, sự đối lưu do việc khuấy giúp các ion Au (III) từ lòng dung dịch vận chuyển đến bề mặt điện cực được tốt hơn, khi đó nồng độ ion tại ranh giới bề mặt điện cực và dung dịch được đồng nhất và cân bằng với nồng độ ion trong lòng dung dịch trong suốt quá trình điện phân. Do vậy, điều kiện khuấy được lựa chọn trong quá trình tạo AuNP.
3.1.3. Sự tạo thành AuNP trên bề mặt GCE

Hình 3. 4. Giản đồ XRD của AuNP điện kết tủa lên bề mặt GCE ở các điều kiện E = 0,5 V trong 600 giây
Cấu trúc tinh thể lớp vàng nano được nghiên cứu bằng phương pháp nhiễu xạ tia X. Kết quả thu được trên hình cho thấy lớp vàng trên bề mặt GCE có cấu trúc đa tinh thể bao gồm: Au (110), Au (111), Au (200), Au (210) tương ứng với các vị trí góc 34,5o; 38,3o; 48,3o; 53,7o trong đó phần lớn là cấu trúc tinh thể Au (110) [165,166]. Kết quả này cũng phù hợp với kết quả của nhóm tác giả khác khi nghiên cứu kết tủa AuNP lên bề mặt GCE bằng phương pháp điện hóa [167].
Thành phần cấu trúc của lớp AuNP được chế tạo có ảnh hưởng đáng kể đến độ bền của lớp SAM biến tính trên đó. Do đó, khi sử dụng phương pháp khử hấp phụ
điện hóa đối với SAM thiol trên một số loại vàng đơn tinh thể thì thế khử hấp phụ phản ánh năng lượng Gibbs đối với tinh thể Au(110) ở mức thế âm nhất [168]. Do đó, kết quả XRD ở trên cho thấy AuNP chế tạo có thành phần chủ yếu là tinh thể Au
(110) sẽ có lợi cho độ bền của SAM biến tính ở bước tiếp theo. Kết quả này phù hợp với kết quả đo khử hấp phụ điện hóa được trình bày ở mục 3.3.
3.2. Tạo composit AuNP-GO trên bề mặt GCE
Ngoài việc chế tạo AuNP, việc chế tạo composit AuNP-GO để biến tình bề mặt vật liệu nền GCE với tác dụng không chỉ làm tăng diện tích hoạt động bề mặt điện cực so với AuNP mà còn có thể tạo ra khả năng tăng độ bám dính mang lại nhiều ưu việt hơn cho loại vật liệu composit biến tính bề mặt vật liệu nền.
3.2.1. Các phương pháp tạo AuNP-GO trên bề mặt GCE
Để chế tạo điện cực composit AuNP-GO/GCE, ngoài việc điện cực GCE được áp thế +0,5 V trong dung dịch HAuCl4 nhằm kết tủa vàng lên bề mặt điện cực thì một số phương pháp thường được sử dụng nhằm đưa GO lên bề mặt điện cực để tạo composit AuNP-GO đã được khảo sát và so sánh, cụ thể như sau:
Phương pháp 1: Áp thế kết tủa đồng thời điện cực GCE trong hỗn hợp dung dịch HAuCl4 + GO tại thế +0,5 V trong 600 giây (PP1).
Phương pháp 2: Điện cực GCE được quét CV trong dung dịch GO với khoảng thế từ 0 đến -1,65 V, sau đó điện cực được phân cực trong dung dịch HAuCl4 tại thế
+0,5 V với thời gian 600 giây (PP2).
Phương pháp 3: Nhỏ GO lên bề mặt GCE, để khô tự nhiên sau đó phân cực trong dung dịch HAuCl4 tại thế +0,5 V với thời gian 600 giây (PP3).
Các điện cực sau khi chế tạo được nghiên cứu đặc tính điện hoá nhờ quét CV trong dung dịch K3(Fe(CN)6) 5 mM/PBS 0,1 M pH = 7. Kết quả thu được sẽ cho biết tính chất điện hóa của điện cực và tính thuận nghịch của phản ứng điện hóa xảy ra trên điện cực. Mặt khác, từ giá trị dòng píc của đường Von-Ampe có thể so sánh diện tích bề mặt hoạt động điện hóa của các điện cực chế tạo thông qua phương trình Randles – Sevcik. Đây là phương trình thể hiện mối liên hệ giữa dòng píc, nồng độ chất, tốc độ quét thế và hệ số khuếch tán.

. Đường CV của các điện cực chế tạo bằng phương pháp khác nhau: PP1 (■), PP2 (▲), PP3 (▼) và AuNP/GCE (●) trong dung dịch K3(Fe(CN)6) 5 mM/PBS 0,1 M pH=7 với tốc độ quét 0,1 V/s.
Từ kết quả dạng đường Von-Ampe ghi được cho thấy khuếch tán đến toàn bộ bề mặt điện cực là dạng khuếch tán phẳng bao phủ toàn bộ điện cực chứa các thành phần nano. Trong quá trình xảy ra phản ứng điện hóa, sự khuếch tán phẳng của các chất điện hoạt đến bề mặt điện cực không kịp bù đắp lại lượng chất đã tiêu hao, do đó dòng đo được giảm dần về giá trị 0 khi thời gian đo kéo dài và kết quả là đường Von-Ampe quét thế vòng thu được sẽ có dạng píc như trên hình 3.5 [169].
Phản ứng điện hóa xảy ra trên điện cực khi quét CV trong dung dịch K3(Fe(CN)6 5 mM/PBS 0,1 M pH=7 với tốc độ quét 0,1 V/s là:
K3(Fe(CN)6) + 1e ⇌ K4(Fe(CN)6 (3.1)
Theo lý thuyết điện hóa, hiệu thế đỉnh píc của píc oxi hóa và píc khử ở điều kiện t= 25oC, p = 1 atm) của phản ứng thuận nghịch được suy ra từ phương trình Nernst là:
∆E = Epa - Epc = 0,059
𝑛
(3.2)
Từ đường CV của các điện cực xuất hiện một píc khử tại khoảng thế 0,19 V, píc này tương ứng với sự khử Fe (III) → Fe (II). Píc oxi hóa xuất hiên trên đường Von-
Ampe tại khoảng thế 0,25 V tương ứng với sự oxi hóa Fe (II) → Fe (III). Như vậy hiệu thế đỉnh píc là : ∆E = 0,25-0,19 = 0,06 V, suy ra n 1. Kết quả này phù hợp với đặc tính của phản ứng thuận nghịch, tức là hệ Fe (III)/Fe (II) đều xảy ra thuận lợi trên các điện cực chế tạo và các điện cực đều hoạt động điện hóa tốt.
Từ kết quả dòng ghi được trên đường Von-Ampe của các điện cực sẽ tính được diện tích bề mặt hoạt động điện hóa của điện cực thông qua phương trình Randles – Sevcik:
Ip = (2,69.105). n3/2. Shđ. D1/2. C. v1/2 (3.3)
Trong đó:
Ip: dòng píc (A) F: hằng số Faraday D: hệ số khuếch tán (cm2/s) Shđ: diện tích bề mặt hoạt động điện hóa điện cực (cm2)
C: nồng độ (mol/cm3) ν: tốc độ quét thế (V/s) n: số electron trao đổi trong quá trình oxi hóa khử
Diện tích bề mặt hoạt động điện hóa điện cực, Shđ của điện cực được tính theo phương trình 3.3 từ giá trị dòng píc đo được trên đường Von – Ampe và các giá trị n, D, C, ν đã biết.
Bảng 3. 1. Giá trị cụ thể của các thông số trong phương trình Randle – Sevcik
D (cm2/s) | n | v (V/s) | |
5.10-6 | 7,5.10-6 | 1 | 0,1 |
Có thể bạn quan tâm!
-
Ảnh Sem Các Điện Cực Aunp Được Chế Tạo Bằng Các Phương Pháp Khác Nhau: Áp Thế Cố Định (A) [117], Quét Thế Vòng (B) [120], Hấp Phụ Hóa Học (C) [ -
(A) Sự Biến Thiên Thế Theo Thời Gian, (B) Dạng Đường Von-Ampe Hòa Tan Trong Kỹ Thuật Von-Ampe Xung Vi Phân. -
Chế Tạo Các Sam Biến Tính Lớp Aunp Trên Điện Cực Gce -
Diện Tích Hoạt Động Điện Hóa Của Điện Cực Aunp/gce Và Aunp- Go/gce -
Cơ Sở Lý Thuyết Sử Dụng Sam Biến Tính Điện Cực Phân Tích Hg (Ii) -
Sự Biến Đổi Dòng Píc Hg (Ii) Ở Nồng Độ 1 Ppb Theo Số Lần Sử Dụng Của Điện Cực Pet-Sam/aunp
Xem toàn bộ 138 trang tài liệu này.
Píc được sử dụng tính toán là píc khử Fe(III) → Fe(II), có giá trị dòng píc là
Ip. Kết quả tính toán thu được, trình bày trên bảng 3.1.
Bảng 3. 2. Kết quả nghiên cứu các phương pháp chế tạo composit
Chiều cao pic Ipc (µA) | Diện tích bề mặt hoạt động điện hóa (Shđ) (cm2) | Tỉ số Shđ / Shh | |
PP1 | 153,753 | 0,132 | 1,859 |
PP2 | 107,201 | 0,091 | 1,281 |
PP3 | 88,401 | 0,075 | 1,056 |
AuNP/GCE | 121,203 | 0,104 | 1,464 |
Kết quả thu được thể hiện như trên bảng 3.2 cho thấy composit AuNP- GO/GCE chế tạo theo PP1 cho diện tích bề mặt hoạt động điện hóa lớn nhất, sự tăng diện tích bề mặt hoạt động điện hóa so với diện tích hình học (Shh) của điện cực nền là 1,859 lần. Chính vì vậy, PP1 được lựa chọn để chế tạo composit AuNP-GO trên nền GCE.
3.2.2. Các yếu tố ảnh hưởng đến việc tạo composit AuNP-GO
Các yếu tố ảnh hưởng đến việc tạo composit AuNP-GO sẽ làm thay đổi cấu trúc bề mặt điện cực biến tính, và do đó sẽ ảnh hưởng đến độ nhạy phát hiện Hg(II) như được trình bày dưới đây.
٭ Ảnh hưởng của nồng độ muối vàng, lượng GO phân tán và thời gian áp thế điện kết tủa
Hình 3. 6. Ảnh hưởng của nồng độ muối vàng (a), lượng GO phân tán (b) và thời gian áp thế điện kết tủa (c) đến tín hiệu dòng Hg (II)
Để khảo sát nồng độ muối vàng và lượng GO phân tán trong hỗn hợp dung
dịch Au (III)+GO đến tín hiệu dòng, nghiên cứu được thực hiện bằng cách quét DPVA sử dụng điện cực PET-AET-SAM/AuNP-GO với lượng GO khảo sát từ 8.10- 5 mg/ml đến 8.10-3 mg/ml và nồng độ vàng khảo sát từ 0,5 mM đến 10 mM. Kết quả được trình bày như trên hình 3.6.
Kết quả thu được trên hình 3.6 (a) và 3.6 (b) cho thấy tín hiệu dòng thủy ngân có xu hướng tăng khi tăng dần nồng độ Au (III) và lượng GO phân tán đến 2 mM và 8.10-4 mg/ml tương ứng, sau đó tín hiệu giảm dần. Khi áp thế kết tủa trong hỗn hợp Au (III) +GO, tăng dần nồng độ HAuCl4 thì lượng vàng đến bề mặt điện cực càng lớn, cùng với đó khi tăng dần lượng GO thì các vị trí tương tác trên bề mặt vàng càng
lớn, điều này làm cho sự kết hợp giữa các hạt vàng lân cận trở nên nhanh hơn, điểm tới hạn cho nồng độ Au (III) và lượng GO mà tại đó cấu trúc sắp xếp tốt nhất làn lượt là 2 mM và 8.10-4 mg/ml và tín hiệu thủy ngân thu được là lớn nhất. Khi nồng độ Au
(III) và lượng GO tăng vượt quá 2 mM và 8.10-4 mg/ml dẫn đến sự kết tụ các hạt vàng lân cận tạo nên cấu trúc khối làm giảm diện tích hoạt động bề mặt điện cực dẫn đến tín hiệu dòng thủy ngân giảm dần. Kết quả này cũng tương tự khi kéo dài thời gian điện phân vượt quá 600 giây như thể hiện trên hình 3.6 (c).
Bởi vậy, nồng độ Au (III) là 2 mM, lượng GO phân tán 8.10-4 mg/ml và thời gian điện phân 600 giây được lựa chọn cho các nghiên cứu tiếp theo.
٭. Ảnh hưởng của pH dung dịch điện phân
Sự phụ thuộc của tín hiệu Hg(II) vào pH của dung dịch điện phân cũng được khảo sát, kết quả được thể hiện trên hình 3.7.

Hình 3. 7. Ảnh hưởng của pH dung dịch điện phân đến tín hiệu thủy ngân
Kết quả cho thấy tín hiệu dòng Hg(II) ở pH > 6 lớn hơn so với dòng khi pH <
6, các nhóm chức GO deproton hóa nên GO ưa nước và phân tán tốt hơn tạo điều kiện thuận lợi cho quá trình tạo composit. Kết quả thu được tương tự với kết quả nghiên cứu của D. Blankschtein và cộng sự [170]. Bởi vây, pH = 6 được lựa chọn là điều kiện tối ưu cho các nghiên cứu tiếp theo.
3.2.3. Cấu trúc bề mặt composit AuNP-GO trên bề mặt GCE
Sự có mặt của GO trong composit biến tính bề mặt GCE được nghiên cứu bằng phương pháp FTIR. Hình 3.8 so sánh phổ FTIR của AuNP/GCE và AuNP- GO/GCE đã chế tạo.
Khác với AuNP/GCE (hình 3.8 (a)), trên phổ của AuNP-GO/GCE có xuất hiện các píc cho thấy sự tồn tại của các liên kết tại nhóm chức -C=O ở 1742 cm-1, -COOH ở 1672 cm-1, hay C-O-C ở vị trí 1183 cm-1 và 1303 cm-1(hình 3.8 (b)) [171]. Ngoài ra, các liên kết C-H ở 1028 cm-1 và C-C ở vị trí 762 cm-1 của vòng benzen cũng xuất hiện [172,173]. Các kết quả này rò ràng cho thấy GO trong dung dịch được dịch chuyển lên bề mặt GCE nhờ quá trình đối lưu và tham gia cộng kết với AuNP trên bề mặt GCE trong quá trình điện phân.

Hình 3. 8. Phổ FTIR của AuNP/GCE (a) và AuNP-GO/GCE (b)
Để đánh giá được ưu điểm khi thêm GO đến việc tạo composit AuNP-GO, hình thái cấu trúc của AuNP-GO/GCE được so sánh với hình thái cấu trúc của AuNP/GCE như được trình bày trên hình 3.9.
Kết quả cho thấy hình thái của AuNP phủ trên bề mặt GCE tương đối đồng đều ở kích thước nano mét, sự sắp xếp của AuNP che phủ gần như kín bề mặt và tạo nên bề mặt tương đối phẳng (hình 3.9 (a)). Khi AuNP-GO được phủ trên bề mặt GCE, ngoài việc tạo các hạt vàng có kích thước nano mét, bề mặt gồ ghề có cấu trúc nano mét của lớp vàng phủ trên bề mặt GCE đã được tạo ra (hình 3.9 (b)) do cách sắp xếp

![Ảnh Sem Các Điện Cực Aunp Được Chế Tạo Bằng Các Phương Pháp Khác Nhau: Áp Thế Cố Định (A) [117], Quét Thế Vòng (B) [120], Hấp Phụ Hóa Học (C) [](https://tailieuthamkhao.com/uploads/2022/07/13/nghien-cuu-bien-tinh-dien-cuc-than-thuy-tinh-bang-vat-lieu-co-cau-truc-nano-6-1-120x90.jpg)




